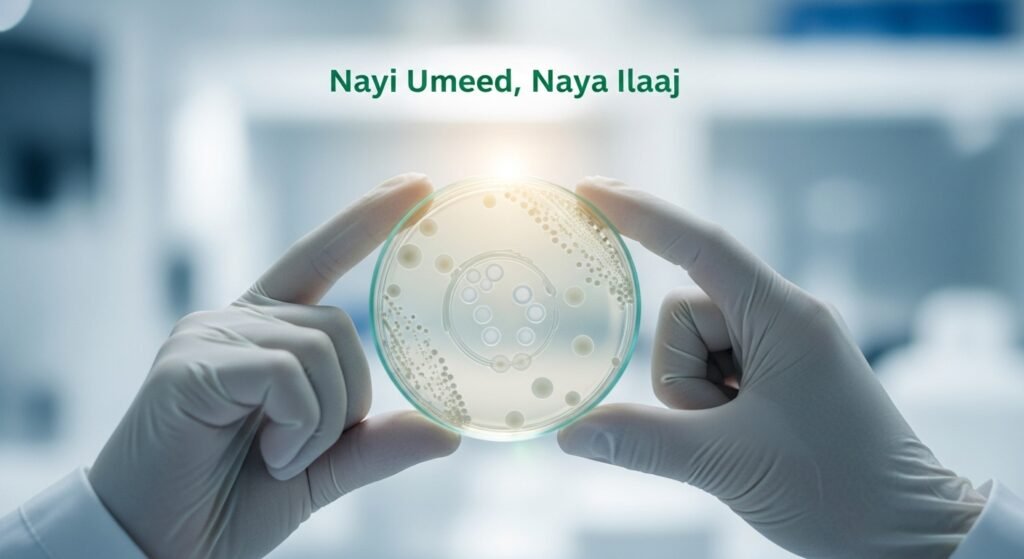
Deaths from Antibiotic-Resistant Infections to Rise Sharply by 2050, Study Warns startupurdu.com

Deaths from Antibiotic-Resistant Infections to Rise Sharply by 2050, Study Warns
Dunya is waqt ek aisi “khamosh waba” (silent pandemic) ki lapait mein hai jo aahista aahista hamari tibbi (medical) salahiyaton ko khatam kar rahi hai. Ek nayi aur jame (comprehensive) tehqeeq ne khabardar kiya hai ke antibiotic-resistant bacterial infections (antibiotics se be-asar honay walay bacterial infections) se honay wali amwaat 2050 tak khatarnak had tak barh sakti hain. Yeh report na sirf aane walay khatray ki nishandahi karti hai balke is se bachne ke liye fori iqdamaat ki zaroorat par bhi zor deti hai.
A Deep Dive into the Data (Data Ka Gehra Tajziya)
Institute of Health Metrics and Evaluation ki Eve Wool aur unki team ki taraf se ki gayi yeh tehqeeq is mauzu par ab tak ki sab se barri analysis hai. Is mein 1990 se 2021 tak ke 500 million se zayed records ka jaiza liya gaya hai. Tehqeeq ke mutabiq, 2019 mein is qism ke infections se barah-e-raast (directly) 1.27 million amwaat hui theen. Report mein “sab se zyada imkaan walay scenario” ke tehet paishgoi (prediction) ki gayi hai ke yeh sharah 2050 tak barh kar 1.91 million salana ho sakti hai. Iska matlab hai ke aglay 25 saalon mein kul 39 million log aisi beemarion se mar sakte hain jin ka ilaaj pehle mumkin tha.
A Tale of Two Age Groups (Do Mukhtalif Umron Ki Kahani)
Is report ka sab se dilchasp pehlu yeh hai ke yeh khatra har umar ke fard par yaksaan (equally) asar andaaz nahi ho raha. Report ke mutabiq:
- Bachon Mein Kami: 5 saal se kam umar ke bachon mein in infections se honay wali amwaat mein 50% se zayed ki kami dekhi gayi hai. Iski wajah behtar vaccines aur bachon ki behtar dekh bhal hai.
- Baron Mein Izafa: Iske bar-aks (in contrast), 70 saal se zayed umar ke afrad mein amwaat ki sharah mein 80% ka khatarnak izafa hua hai.
Yeh adad-o-shumar zahir karte hain ke jahan tibbi taraqqi ne bachon ko mehfooz kiya hai, wahin barhti umar ke logon ke liye antibiotic-resistant bacterial infections ka khatra barh gaya hai.
The COVID-19 Anomaly (COVID-19 Ka Ghair Mamooli Asar)
Tehqeeq mein yeh bhi bataya gaya ke 2021 mein amwaat ki sharah mein mamooli kami (1.14 million tak) dekhi gayi. Mahireen ke mutabiq, iski wajah COVID-19 ke douran apnaye gaye hifazati iqdamaat thay, jaise ke mask pehenna aur social distancing, jinki wajah se deegar bacterial infections bhi kam phaile. Taham, yeh kami aarzi (temporary) thi aur ab khatra dobara barh raha hai.

Is There Hope on the Horizon? (Kya Umeed Ki Koi Kiran Hai?)
Report mein sirf khatray ki nishandahi nahi ki gayi, balke umeed ki kiran bhi dikhayi gayi hai. Mahireen ka kehna hai ke agar fori aur musir (effective) iqdamaat kiye jayein, to 2050 tak honay wali amwaat mein se ek tihai (one-third) se zayed ko roka ja sakta hai. Iske liye zaroori hai ke:
- Nayi antibiotics tayyar ki jayein.
- Healthcare systems ko behtar banaya jaye.
- Infections ki rok thaam ke liye behtar iqdamaat kiye jayein. Yeh is baat ka ishara hai ke abhi bhi waqt hai, lekin is “khamosh waba” se larnay ke liye aalmi satah par fori action ki zaroorat hai, taake how to prevent antibiotic resistance deaths ke sawal ka jawab dhoonda ja sake.
Challenges and Future Outlook (Challenges aur Mustaqbil Ka Manzarnama)
Mahireen is baat ko bhi tasleem karte hain ke yeh paishgoiyan hain aur in mein ghair-yaqeeni (uncertainty) ka anasir shamil hai. Dunya bhar mein khatraat mukhtalif ho sakte hain aur bacteria ki tabdeeli ka andaza lagana mushkil hai. Taham, yeh tehqeeq ek ahem warning bell hai jo dunya ko is barhte hue khatray se aagah kar rahi hai taake is se nimatne ke liye tayyari ki ja sake.


